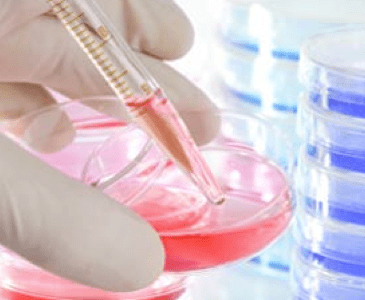

Whole genome sequencing is medicine’s Snowy Scheme (The Australian)
John Mattick (1), Branwen Morgan (2) (1) Executive Director, Garvan Institute of Medical Research, Sydney (2) Visiting Fellow, Garvan Institute of Medical Research, Sydney We are on the brink of a revolution in healthcare. Genomics soon will help us not just cure but also predict and even prevent diseases such as diabetes, dementia, cancer and … More Whole genome sequencing is medicine’s Snowy Scheme (The Australian)